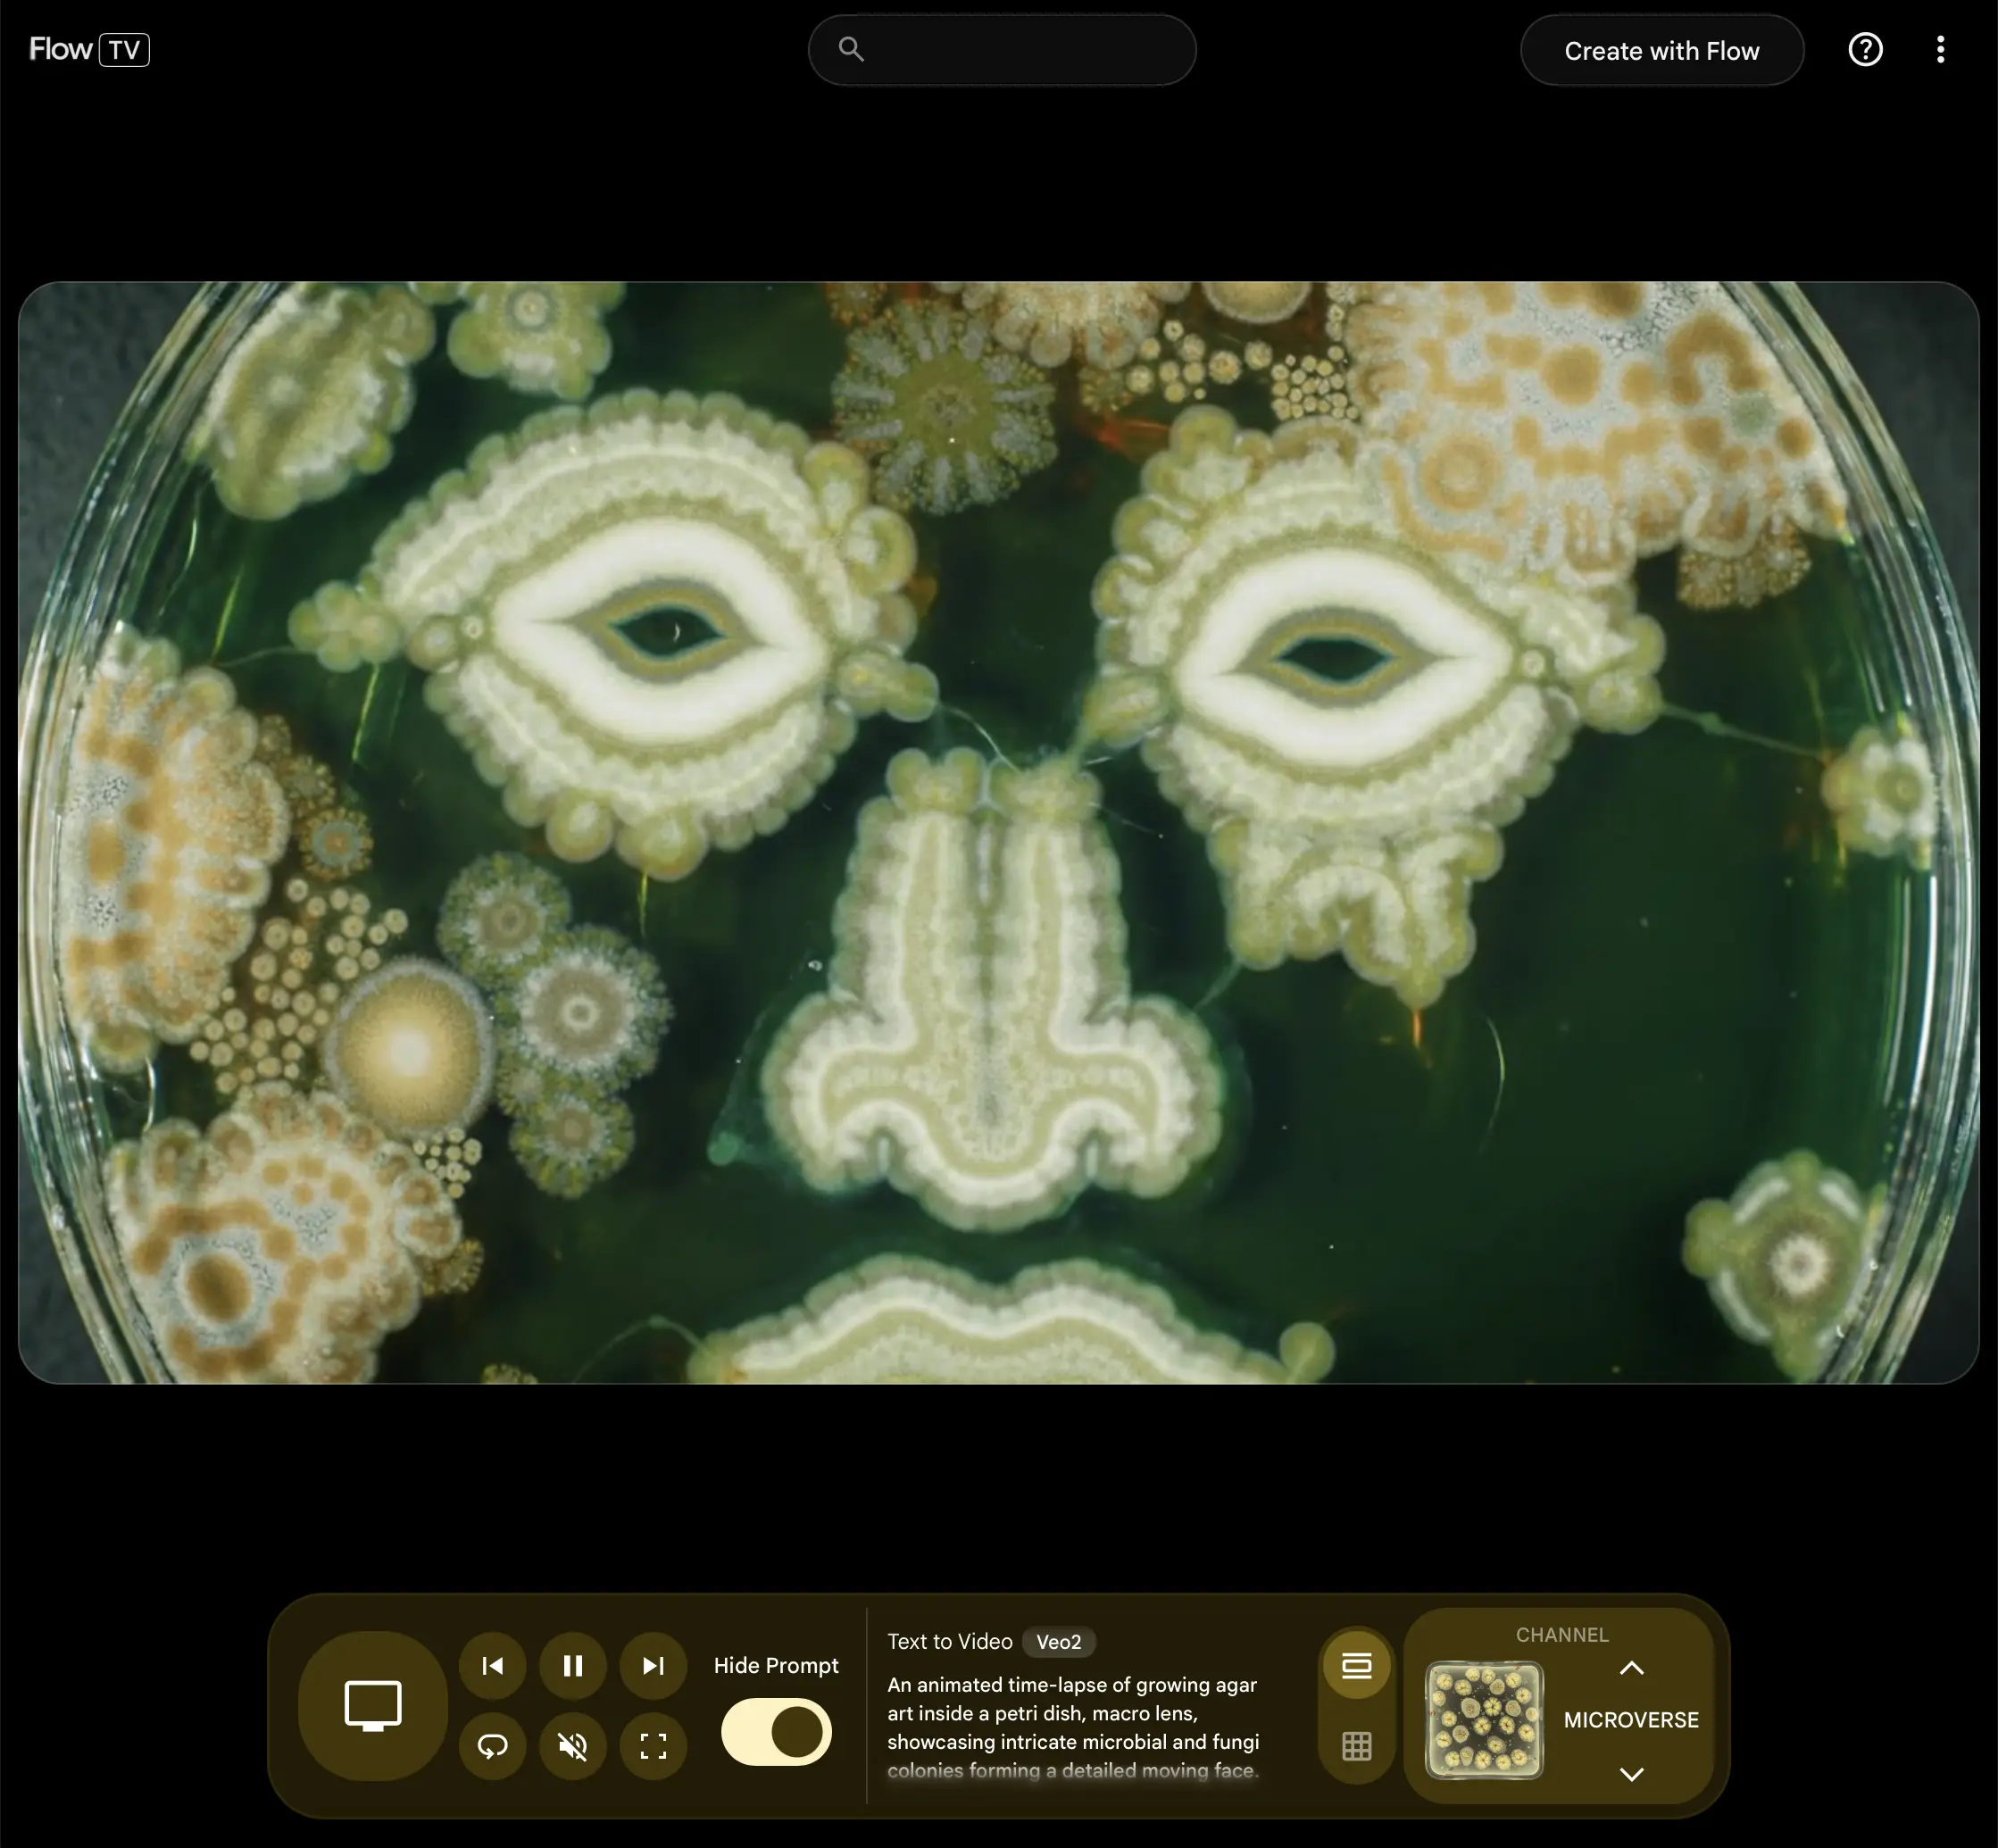

เครื่องมือ AI สร้างวิดีโอภาพยนต์จากข้อความคำสั่ง Flow ได้เปิดให้บริการในไทยแล้ว จะมีรายละเอียดเงื่อนไขการใช้งานอย่างไรบ้าง ไปดูกัน!
Flow เปิดให้ใช้บริการในไทยแล้ว!
เมื่อช่วงเดือน พ.ค. ที่ผ่านมา งาน Google I/O 2025 เปิดตัว AI Generate Media ใหม่ ชื่อว่า Flow พร้อมให้บริการได้ภายในบางประเทศซึ่งในตอนนั้นประเทศไทยยังไม่สามารถใช้งานได้ แต่เมื่อไม่กี่วันที่ผ่านมา ผู้ใช้งานในไทยสามารถใช้งานได้แล้ว

Flow เป็นเครื่องมือสร้างวิดีโอระดับภาพยนต์ ที่ระหว่าง Veo 3 กับ Imagen 4 ของ Google DeepMind โดยรองรับการสร้างโดยเขียนข้อความคำสั่ง (Text to Video), นำเข้าภาพและแปลงให้เป็นวิดีโอ (Frames to Video) และพิเศษสำหรับผู้ที่ใช้ Google Ultra มีฟังก์ชัน (Ingredients video) ช่วยผสานวิดีโอโดยนำโปรเจกงานที่มีอยู่แล้ว กับของโปรเจกต์งานใหม่ ให้เข้ากันอย่างลงตัว
ฟังก์ชันการควบคุมการเคลื่อนไหวของกล้อง มุมกล้องของวิดีโอ (Camera Control) สามารถขยายสูงสุดที่ 1080p ความคมชัดของวิดีโอ

บนหน้าเว็ปไซต์มี Flow TV ตัวอย่างของผลลัพธ์ พร้อมรายละเอียด Prompt ในการสร้างผลลัพธ์ เป็นแนวทางในการสร้างวิดีโอต่าง ๆ ที่หลากหลายให้กับผู้ใช้

รายละเอียดเกี่ยวกับการให้บริการ Flow เปิดให้ใช้บริการสำหรับผู้ที่ชำระเงินสมัครใช้งาน Google AI ระดับ Pro/Ultra เท่านั้น รายละเอียดดังนี้


• Google AI Pro: 750 บาท/เดือน (ฟรีเดือนแรก) ได้ 1,000 เครดิต/เดือน
• Google AI Ultra: 9,400 บาท/เดือน (4,700 บาท/เดือนใน 3 เดือนแรก) ได้ 12,500 เครดิต/เดือน
ที่มา: Flow, Google Labs Help
